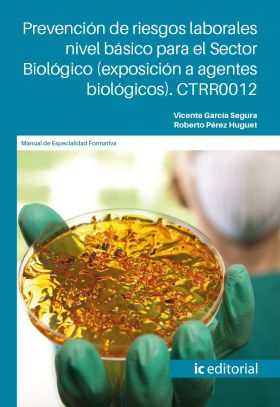
PREVENCION DE RIESGOS LABORALES NIVEL BASICO PARA EL SECTOR BIOLOGICO (EXPOSICIO

PREVENCION DE RIESGOS LABORALES NIVEL BASICO PARA EL SECTOR BIOLOGICO (EXPOSICIO
Autor: PEREZ HUGUET, ROBERTO
Sección: DERECHO - Códigos legales
PREVENCION DE RIESGOS LABORALES NIVEL BASICO PARA EL SECTOR BIOLOGICO (EXPOSICIO
21,84€ IVA INCLUIDO
- Editorial:
- -
- Publicación:
- 01/01/2026
- Colección:
- COMPETENCIA TRANSVERSAL
- Ver ficha completa
Sinopsis
Objetivos - Aplicar los conceptos en materia de prevención de riesgos laborales (PRL), generales y específicos, que acerquen al conocimiento de la ley, de los derechos y obligaciones legales, de los riesgos y de las medidas preventivas. - Identificar la normativa, las responsabilidades, los derechos y las obligaciones de empresarios, mandos y trabajadores en materia de prevención, comprendiendo los conceptos …
Más libros de PEREZ HUGUET, ROBERTO
-

NO DISPONIBLE
EFICIENCIA ENERGETICA EN LA INDUSTRIA FRIGORIFICA. ENAC022PO
PEREZ HUGUET, ROBERTO12,12€ IVA INCLUIDO
-

NO DISPONIBLE
PREVENCION DE RIESGOS LABORALES NIVEL BASICO PARA EL SECTOR ALTA TENSION. CTRR00
PEREZ HUGUET, ROBERTO21,27€ IVA INCLUIDO
-

NO DISPONIBLE
ECONOMIA CIRCULAR: PRINCIPIOS DE LA SOSTENIBILIDAD. SEAG0003
PEREZ HUGUET, ROBERTO8,42€ IVA INCLUIDO
-

NO DISPONIBLE
OPERACIONES AUXILIARES DE MANTENIMIENTO DE SISTEMAS MICROINFORMATICOS. IFCT0108
PEREZ HUGUET, ROBERTO24,18€ IVA INCLUIDO
-

NO DISPONIBLE
MERCADO ENERGETICO Y CONTRATACION DE LA ENERGIA. ENAL005PO
PEREZ HUGUET, ROBERTO22,57€ IVA INCLUIDO
-

NO DISPONIBLE
PREVENCIÓN DE RIESGOS LABORALES NIVEL BÁSICO PARA EL SECTOR OBRAS (CONSTRUCCIÓN,
ROBERTO PÉREZ HUGUET20,96€ IVA INCLUIDO
-

NO DISPONIBLE
PREVENCION DE RIESGOS LABORALES NIVEL BASICO PARA EL SECTOR SANITARIO. CTRR0012
PEREZ HUGUET, ROBERTO20,28€ IVA INCLUIDO
-

NO DISPONIBLE
OPTIMIZACION DE RUTAS DE REPARTO A DOMICILIO. COML0009
PEREZ HUGUET, ROBERTO9,20€ IVA INCLUIDO
-

NO DISPONIBLE
PREVENCION DE RIESGOS LABORALES NIVEL BASICO PARA EL SECTOR EXPLOSIVOS. CTRR0012
PEREZ HUGUET, ROBERTO20,54€ IVA INCLUIDO
-

NO DISPONIBLE
PREVENCION DE RIESGOS LABORALES NIVEL BASICO PARA EL SECTOR QUIMICO. CTRR0012
PEREZ HUGUET, ROBERTO20,70€ IVA INCLUIDO
-

NO DISPONIBLE
EJECUCION DE PROYECTOS DE IMPLANTACION DE INFRAESTRUCTURAS DE REDES TELEMATICAS.
PEREZ HUGUET, ROBERTO25,38€ IVA INCLUIDO
-

NO DISPONIBLE
HERRAMIENTAS PARA LA ORGANIZACION DEL TIEMPO. CTRG0006
PEREZ HUGUET, ROBERTO11,02€ IVA INCLUIDO
-

NO DISPONIBLE
ORGANIZACION DE REUNIONES VIRTUALES. CTRD0002
PEREZ HUGUET, ROBERTO8,74€ IVA INCLUIDO
Más información del libro
PREVENCION DE RIESGOS LABORALES NIVEL BASICO PARA EL SECTOR BIOLOGICO (EXPOSICIO
- Editorial:
- -
- Fecha Publicación:
- 01/01/2026
- Formato:
- Normal tapa blanda (libros)
- ISBN:
979-13-7027-108-4
- EAN:
9791370271084
- Nº páginas:
- 262
- Colección:
- COMPETENCIA TRANSVERSAL
- Lengua:
- ESPAÑOL
- Alto:
- 24 mm
- Ancho:
- 17 mm
- Sección:
- DERECHO
- Sub-Sección:
- Códigos legales
PEREZ HUGUET, ROBERTO
Otros libros en DERECHO
-

DISPONIBLE
Recogida en librería GRATIS
Envío a domicilio
CONSTITUCIÓN ESPAÑOLA
VV.AA.11,50€ IVA INCLUIDO
-

DISPONIBLE
Recogida en librería GRATIS
Envío a domicilio
Bajo las togas
CASTRESANA, CARLOS23,00€ IVA INCLUIDO
-

DISPONIBLE
Recogida en librería GRATIS
Envío a domicilio
CODIGO CIVIL (LEYITBE)
Aranzadi LA LEY10,95€ IVA INCLUIDO
-

DISPONIBLE
Recogida en librería GRATIS
Envío a domicilio
CODIGO PENAL (LEYITBE)
Aranzadi LA LEY10,95€ IVA INCLUIDO
-

DISPONIBLE
Recogida en librería GRATIS
Envío a domicilio
Ley de Enjuiciamiento Civil (LeyItBe)
Aranzadi LA LEY12,95€ IVA INCLUIDO
-

DISPONIBLE
Recogida en librería GRATIS
Envío a domicilio
LA CONSTI VERSION MARTINA. EDICION COTTON CANDY
Valera, Vicente20,95€ IVA INCLUIDO
-

ÚLTIMOS EJEMPLARES
Recogida en librería GRATIS
Envío a domicilio
CURSO DE DERECHO FINANCIERO Y TRIBUTARIO
AA.VV.65,95€ IVA INCLUIDO
-

NO DISPONIBLE
ESTUDIO SOBRE LA PROTECCIÓN DE DATOS (E-BOOK)
APARICIO SALOM, JAVIER63,16€ IVA INCLUIDO
-

NO DISPONIBLE
Estudio sobre la Protección de Datos (Papel + e-book)
Aparicio Salom, Javier89,47€ IVA INCLUIDO
-

NO DISPONIBLE
Tribunal de Justicia de la Unión Europea, Justicia Civil y Derechos Fundamentale
Aguilera Morales, Marien58,95€ IVA INCLUIDO
-

NO DISPONIBLE
La certificación forestal: un instrumento de mercado del servicio de la gestión
García-Moreno Rodríguez, Fernando73,68€ IVA INCLUIDO
-

NO DISPONIBLE
TRIBUNAL DE JUSTICIA DE LA UNIÓN EUROPEA, JUSTICIA CIVIL Y DERECHOS FUNDAMENTALE
AGUILERA MORALES, MARIEN41,06€ IVA INCLUIDO



























